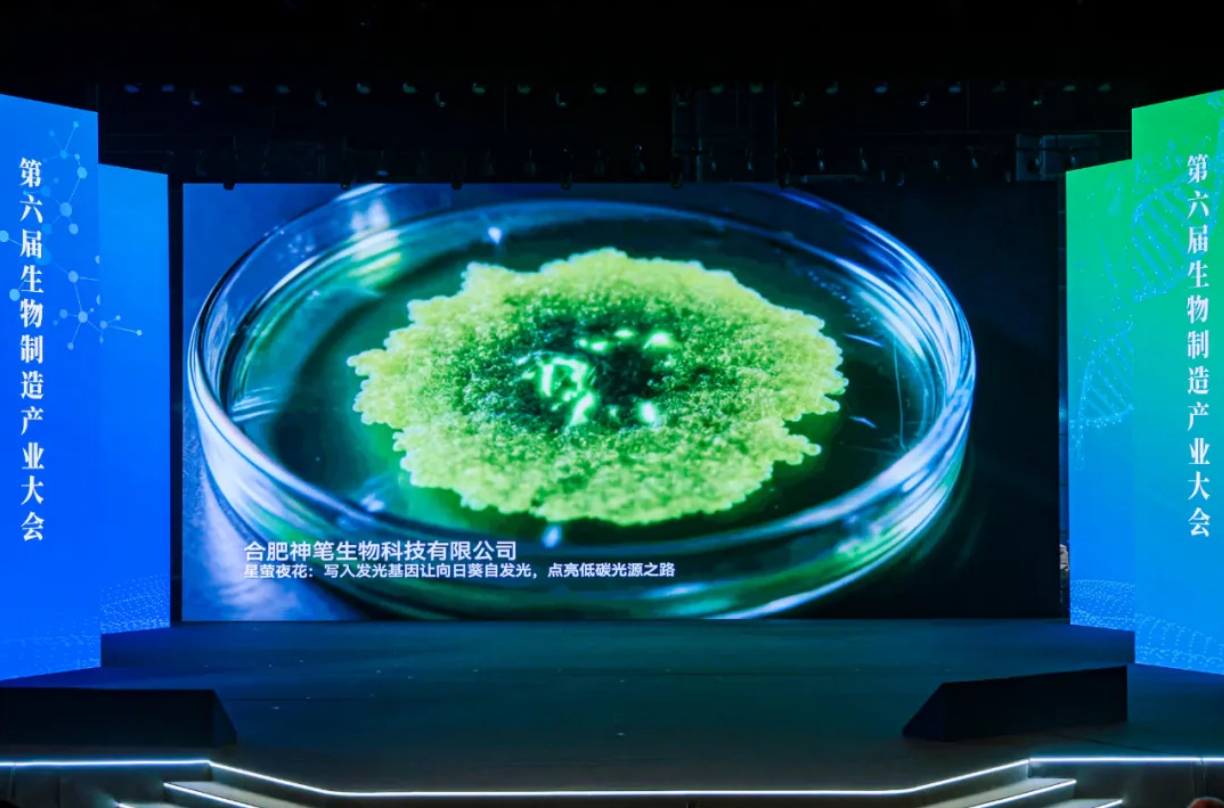
ScreenShot_2026-01-08_114559_109.png

On December 2, 2025, Shenzhen Guangming Culture and Art Center - the 6th Biomanufacturing Industry Conference opened grandly here. The conference was co-sponsored by the China Bioengineering Society and the Shenzhen Institute of Advanced Technology of the Chinese Academy of Sciences, and brought together more than ten national-level institutions, including the National Biomanufacturing Industry Innovation Center and the Shenzhen National High-tech Industry Innovation Center.
At this top event in the field of synthetic biology manufacturing in China, Shenbi Biology presented its innovative achievement - "Star Firefly Night Flower" self-luminous plant to the conference, and was successfully selected into the "Top Ten New Products of Creation 2025" authoritatively released by the conference.
Industry event to jointly draw a blueprint for biomanufacturing
At the opening ceremony of the conference, Dai Yunlong, Director of the Standing Committee of the Shenzhen Municipal People's Congress, Fu Gangfeng, Chairman of the State Development and Investment Group Co., Ltd., Xue Qiang, Director of the Sustainable Development Research Bureau of the Chinese Academy of Sciences, Liu Chenli, Director of the Shenzhen Institute of Advanced Technology, Chinese Academy of Sciences, and other government leaders and industry experts came to the scene and delivered speeches.


This conference has the permanent theme of "Exploring Endless Frontiers and Opening Up a Bright Future" and focuses on the annual topic of "Synthetic Biological Manufacturing, Reshaping Human Life". In the context of the accelerated restructuring of the global biomanufacturing competitive landscape, the conference brings together government, industry, academia, research, and funding forces to implement national strategies in depth and promote the deep integration of technological innovation and industrial innovation.
As one of the six future industries identified by the country, biomanufacturing has been given an unprecedented strategic height in the "15th Five-Year Plan" and is becoming a key force leading a new round of scientific and technological revolution and industrial transformation.
"Creation" 2025 new product: Magic pen star firefly night flower
At the key event of the conference, the "Top Ten New Products of Creation 2025" release site, Chen Xiang, co-founder and CEO of Shenbi Bio, introduced to global attendees the company's innovation that combines natural inspiration and cutting-edge synthetic biology technology - the "Shenbi Star Firefly Night Flower" self-luminous plant.

Chen Xiang introduced to the guests: "We extracted multiple natural luminescence genes from fireflies and luminous mushrooms, and used the gene editing platform technology of 'Magic Pen' to accurately implant them into the life blueprint of plants." He described the unique charm of this technology: "Whenever darkness falls, its petals will emit soft and quiet fluorescence like a nebula, and the veins of the petals will be like a flowing river of light, natural, elegant, and full of vitality."

"This is not just a miracle for viewing," Chen Xiang emphasized. "Our plants do not require electricity and continue to emit light through their own metabolism. It is a vivid exploration of low-carbon lighting in the future. It is also a platform that proves that we can transform the potential of living things into a beautiful reality in a natural and harmonious way."
This selection into the "Top Ten New Products of Creation 2025" is the industry's high recognition of Shenbi's biotechnology innovation and industrialization capabilities. As the second company in the world and the first in China to achieve commercial mass production of luminescent plants, this milestone marks that we have reached the forefront of the world in the field of synthetic biology applications.


Behind the achievements lies the deep accumulation of the company's long-term focus. Shenbi Biotech has always been committed to the in-depth research and development and application of synthetic biology and gene editing technology, and has established a complete platform system from technology research and development to industrial transformation. We are steadily promoting innovative achievements such as "Magic Pen Star Firefly Night Flower" from the laboratory to diverse scenarios such as education and science popularization, cultural and creative experience, home decoration, etc., fulfilling our mission of "integrating technology into life".
Take the pen of nature and paint the light of the future
At present, the synthetic biology industry is facing unprecedented strategic opportunities. With the promulgation and implementation of "Several Provisions on Promoting the Innovative Development of the Synthetic Biology Industry in Shenzhen Special Economic Zone", the industrial ecology will be more complete. With this agreement, Shenbi Biotechnology will continue to deepen technology research and development, expand the application possibilities of luminous plants in more scenarios, and explore a broader boundary of sustainable life technology products.

Chen Xiang expressed the company's vision at the conference: "Magic pen creatures, holding the pen of nature, paint the light of the future. We look forward to allowing more people to experience the beauty of romance and technology that comes from life itself, and use the life form of self-luminous sunflowers to light up new possibilities for low-carbon light sources in the future."

Standing at a key node in the development of the bio-manufacturing industry, Shenbi Bio is using its innovative results to inject new momentum into the high-quality development of China's synthetic biology industry and contribute the wisdom and solutions of Chinese enterprises to the development of the global bio-economy.